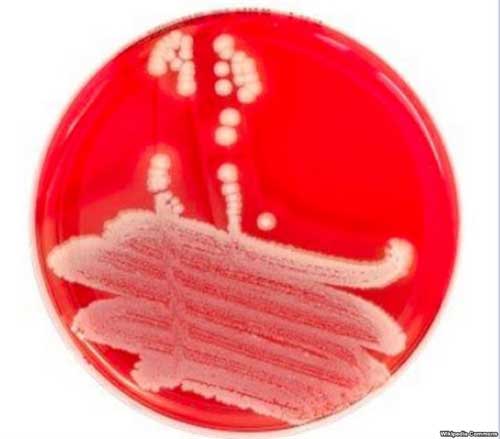
Researchers say anti-bacterial protein, PlyC could be effective antibiotic alternative Designing an alternative to antibiotics

This is the VOA Special English Health Report.
In 1928 a British scientist made a "chance observation." He noticed that somemold had grown in bacteria in a culture plate in his laboratory. Molds can do that. But this mold that had somehow gotten into the plate had the ability to kill the bacteria around it.
The scientist, Alexander Fleming, found that the mold was a member of a common group known as Penicillium. Fleming and two other scientists -- Ernst Boris Chain and Howard Walter Florey -- went on to win the Nobel Prize in 1945. They were honored "for the discovery of penicillin and itscurative effect in various infectious diseases."
Other powerful antibiotics have been discovered since penicillin. But many antibiotics have become less and less effective as the germs they are designed to kill develop resistance.
So scientists are searching for new ways to treat infections. Now, researchers in Australia say they have made an important discovery. Scientists at Monash University in Melbourne believe an antibacterial viral protein called PlyC could be used as an alternative to antibiotics.
This protein was first identified as a possible treatment for infections in 1925. But the research ended following the discovery of antibiotics.
Now, scientists have spent six years studying the structure of the protein. They have found how it kills the bacteria that cause sore throats, pneumonia and streptococcal toxic shock syndrome.
Australian researchers worked with scientists at the Rockefeller University in New York and the University of Maryland. Their findings appear in the Proceedings of the National Academy of Sciences.
Dr. Sheena McGowan from Monash University describes the protein as a powerful bacterial killing machine. She says it looks like a flyingsaucer carrying a pair ofwarheads. It connects to the surface of the bacterium and then cuts through the outside to destroy it.
Sheena McGowan says it could be highly valuable when conditions like pneumonia do not respond to traditional treatments.
SHEENA MCGOWAN: "There's antibiotics at the moment for those particular types of diseases. We sort of see that there's a bit of resistance being built up in the bacterial community almost, and some of our antibiotics aren't quite as effective as they used to be. So this kind of ground route, basic research needs to be done quite early so that we have some time to develop them as safe human therapeutic over the timeframe when the antibiotics can keep working."
The researchers have been studying PlyC's atomic structure to try to develop a drug. They say they have had success in treating streptococcal infections in mice. But an effective human treatment in the form of a pill or nasal spray may be at least ten years away.
And that's the VOA Special English Health Report. I'm Steve Ember.
mold: 霉;霉菌
culture plate: 培養(yǎng)皿
Penicillium: 青霉菌屬
curative: 助于治療的;有療效的
viral protein: 病毒蛋白
pneumonia: 肺炎
streptococcal toxic shock syndrome: 鏈球菌中毒性休克
saucer: 碟形物
warhead: 彈頭
bacterium: 細(xì)菌
timeframe: 時(shí)間段
The Global problem of preterm births
Why getting dirty can be healthy for children
(來(lái)源:VOA 編輯:實(shí)習(xí)生朱眉霖)